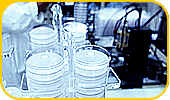
industrie

|
Airprofil versorgt alle Industriebereiche die mit flüssigen Energieträgern arbeiten. Die Firma hat ihre Techniken zunächst unter Berücksichtigung der französischen Energiepolitik in Frankreich entwickelt. Unsere Aktivitäten erstrecken sich nun bis nach Luxemburg, Belgien und Deutschland. |
|
 |
|
|
Die genaue Kenntnis der Vorgänge ist in der Papierindustrie
unerläßlich. Dieser Bereich wird von einem Airprofil-Fachingenieur
abgedeckt.
|
|
| Hilfsentwürfe für
die Konzeption individuellen Druckluftverbrauches von Filtern oder
Druckluftkanonen. LAFARGE. CALCIA. CIMENTS D'ORIGNY. VICAT |
|
|
|
| In der Agrar- und Nahrungsmittelindustrie
bestehen die Aufgaben für EAC in der Verteilungsmessung, sowie
den Untersuchungen für Druckluftinstallationen die Ansteckungsrisiken
verringern (HACCP). BLEDINA. NESTLE PLF. THIVAT NUTRITION ANIMALE |
|
|
Die Automobilindustrie hat sich oft an EAC gewandt um technische
Abmessungen in Aluminiumschmelzen oder Kühlwasseranlagen durchzuführen.
|
|
 |
|
| Druckluftmessungen in besonderen
Anwendungsbereichen, Werkstätten- oder Zentralausgangsaufteilungen. HAGER. SCHNEIDER ELECTRIC. MERLIN GERIN |
|
| CHRISTIAN DIOR PARFUM. LABORATOIRE INDUSTRIEL DE VICHY | |
| EUROCOPTER. SNECMA SERVICES | |
|
Airprofil hat ein Sicherheitsmanagementsystem eingerichtet: Die
Zertifizierung ISO 9000/14000 unserer Produkte befindet sich in
der Durchführungsphase. |